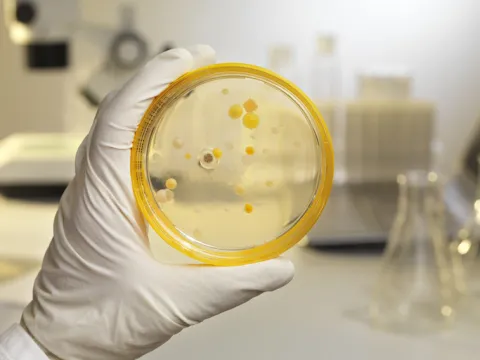
infectious diseases

Powering Pediatric Research and Innovation
AdventHealth for Children is creating the future of pediatric health care through research and data analysis to improve clinical performance and quality of care. Our nationally recognized children's hospital and network of pediatric specialists, programs and care facilities set the standard for innovation, quality and comprehensive care.
Most Recent Stories

Pediatric Research
Our goal at the Center for Pediatric Research is to create the future of pediatric health care through research and data analysis to improve clinical performance and quality of care. We seek to increase the ability of AdventHealth for Children to become a leading children’s network and to extend the healing ministry of Christ.

Clinician's In the News
View the latest media coverage in top local, regional and national clinical and trade publications, as well as prestigious medical organizations, that feature AdventHealth physicians addressing topics such as research, clinical excellence and innovation.

Partnership is in our DNA Rapid Whole Genome Sequencing
AdventHealth for Children is the first and only children's hospital in Central Florida to provide rapid whole genome sequencing, an advanced diagnostic technology, that will rapidly identify the causes of rare genetic disorders in some of the sickest infants and children.
Through a partnership with Rady Children’s Institute for Genomic Medicine, we are able to have access to a state-of-the-art genome sequencing lab that employs a multi-disciplinary team of experts who specialize in providing timely and accurate guidance to physicians caring for children with rare genetic disease. This partnership is the latest in AdventHealth's investment in genomics and will change the future of healthcare.
“Genomics is the future of medicine. This advanced testing can have a significant impact on how we diagnose and treat patients,. Rady Children’s Institute is a leader in genomic medicine, and this partnership will help us provide the best care to some of the littlest and sickest patients in our care.” - Dr. Rajan Wadhawan, Senior Executive Officer, AdventHealth for Children.

Nationally Ranked Pediatric Specialists
With more than 140 pediatric specialists practicing in 35 specialties dedicated to healing children, our team includes many active researchers in their associated fields. We participate in a wide variety of clinical trials and research studies aimed at raising the bar in pediatric care.
Our Accreditations and Rankings
National Leader in Newborn Care
For the 4th time, AdventHealth for Children is recognized by U.S. News & World Report as the best children's hospital for newborn care in Florida.
Nursing Magnet Recognized
AdventHealth for Children holds the gold standard Magnet designation from the American Nurses Credentialing Center.
NAEC Level IV Epilepsy Center
The National Association of Epilepsy Centers (NAEC) designated AdventHealth for Children a Level 4 Epilepsy Center, the top designation for epilepsy centers in the nation. Level 4 epilepsy centers have the professional expertise and facilities to provide the highest level medical and surgical evaluation and treatment for patients with complex epilepsy.
Internationally Recognized Stem Cell Therapy
Our Pediatric Cellular Therapy Program is accredited by the Foundation for the Accreditation of Cellular Therapy (FACT) for meeting the most rigorous quality standards in every aspect of stem cell therapy.

ELSO Center of Excellence Award
AdventHealth for Children is Central Florida's only ELSO (Extracorporeal Life Support Organization) Center of Excellence in Life Support, Platinum Level, in collaboration with AdventHealth. We provide exceptional care to high-risk patients needing specialized life support.